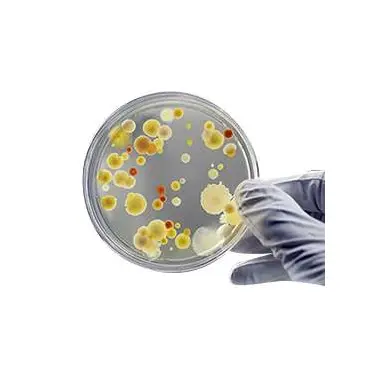

WELCOME TO ALSAFIA PIONEERING CHEMICAL SOLUTIONS FOR A SUSTAINABLE FUTURE
OUR PRODUCTS
OUR PRODUCTS AND SERVICES
At Alsafia, we take pride in offering a comprehensive suite of chemical solutions and services designed to meet the diverse needs of industries worldwide. Our commitment to innovation, sustainability, and excellence is at the core of everything we do, ensuring we deliver value that goes beyond just products and services.

Commitment to Quality and Assurance at Alsafia
At Alsafia, we are committed to leading the way in chemical distribution and water treatment solutions worldwide. Our dedication to innovation and sustainability positions us at the forefront of the chemical industry. Specializing in a broad spectrum of laboratory instruments, chemicals, and water treatment equipment, we excel in delivering quality and precision. Our approach is rooted in swift, reliable service and cost-effective solutions, affirming our role as the preferred partner for industries pursuing excellence and efficiency.

INDUSTRIES WE SERVE
Alsafia collaborates with a diverse array of industries, tailoring chemical solutions to meet the unique requirements of each sector. Our expertise spans across Oil & Gas, Food & Beverage, Personal Care, and Water Treatment industries, ensuring we deliver not just products but comprehensive solutions that address specific industry challenges. By leveraging industry-related semantic keywords, we underscore our commitment to providing targeted solutions that enhance operational efficiency and sustainability.
OUR PRODUCTS
OUR PREMIUM PRODUCTS

Laboratory Refrigerator

BIOLOGICAL SAFETY CABINE

INCUBATOR

CENTRIFUGE

LABORATORY OVEN

CLIMATIC CHAMBER
.webp)
STABILITY CHAMBER (ICH)

HOMOGENIZER
Products Under Construction.
Products Under Construction.

Biohazard Bags
Culture Media

Culture Tubes

Inoculating Loops and Needles

MIC Assay Kit

Petri-Dishes

Set Media Plates

Specimen & Sterile Containers

WHAT COMMUNITY SAYING ABOUT US
Alsafia is a leading provider of laboratory equipment and chemicals, dedicated to ensuring quality and reliability. We offer comprehensive solutions for chemical storage and water treatment, engineered for safety and sustainability. Trust Alsafia to enhance your laboratory's capabilities and meet environmental standards.


